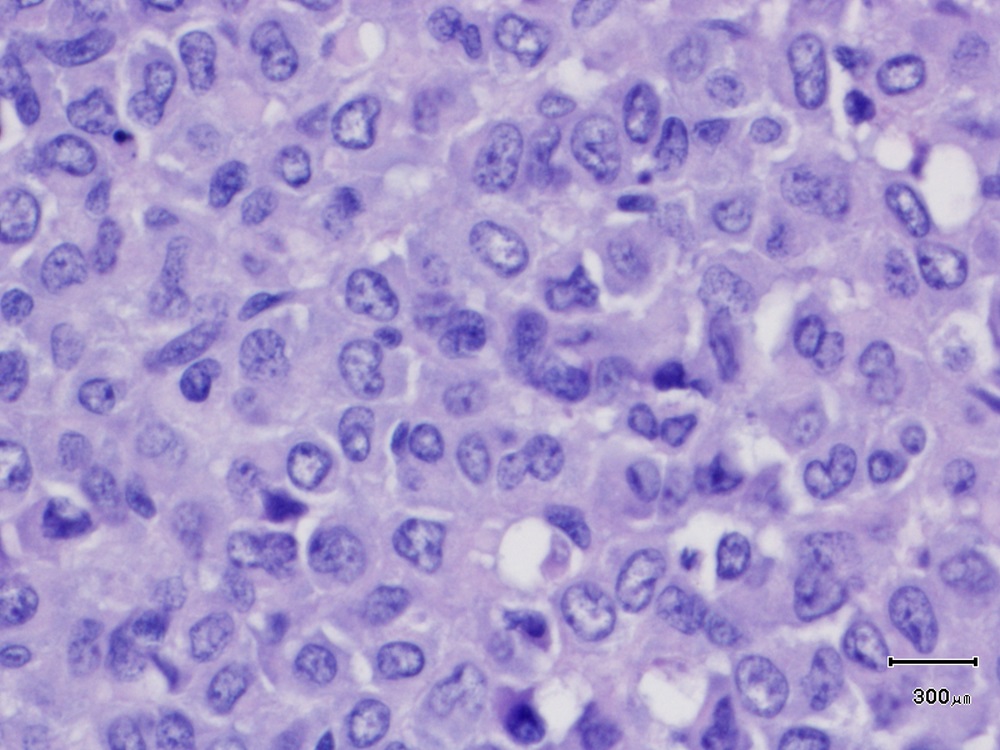

- Home
- Diergezondheid
- Dierziekten
- Osteosarcomen
Osteosarcomen
Osteosarcomen (OSA) zijn maligne neoplasieën van mesenchymale oorsprong. Een (histopathologisch) kenmerk van deze tumoren is de productie van osteoïd. OSA vormen ongeveer 85 procent van alle primaire bottumoren bij de hond. OSA worden vrijwel uitsluitend gezien bij grote of reuzenrassen zoals de Rottweiler, Deense dog, Greyhound, St Bernard en Doberman pinscher.
OSA zijn een heterogene groep tumoren voor wat betreft locatie, locatie van optredende metastasering, radiologisch beeld, histopathologisch subtype, progressie en reactie op behandeling. Predilectieplaatsen zijn de gewichtsdragende gebieden van de langere beenderen (humerus, femur, radius en ulna). Ongeveer 25 procent van de tumoren gaat uit van het axiale skelet zoals de platte beenderen van de schedel, ribben, wervels, sternum en bekken. Daarnaast worden er, ook al is een OSA een bottumor, primaire tumoren beschreven die uitgaan van extra-skeletale weefsels.
OSA zijn agressieve en invasieve neoplasiën, welke lokale destructie van bot veroorzaken, hetgeen op de röntgenfoto kan leiden tot zowel osteolytische laesies als botnieuwvorming. Het is een snel metastaserende tumor, die vooral naar de longen metastaseert, maar ook uitzaaiingen naar andere benige delen, regionale lymfeklieren en andere weke delen komen voor.
Bron: Diergeneeskundig Memorandum Oncologie Gezelschapsdieren 2014
Auteur: Arno Roos (M Sc. Clinical Oncology) met medewerking van Jurgen Tan
Dierziekte informatie Osteosarcomen
- Symptomen
- Diagnose en behandeling
- Casus Jack
- Het nemen en versturen van een botbiopt
- Ontkalkingsprocedures voor bothoudend weefsel
Symptomen van Osteosarcomen
Honden met appendiculair OSA worden meestal aangeboden in verband met kreupelheid. Opvallend vaak wordt door de eigenaren gemeld dat er sprake geweest is van gering trauma waarna de kreupelheid opgevallen is. De oorzaak van de pijn is waarschijnlijk het optreden van microfracturen of de disruptie van het periost ten gevolge van osteolyse van het corticale bot door groei van de tumor. Soms worden honden aangeboden met extreme pijnlijkheid en het zelfs niet gebruiken van een extremiteit doordat een pathologische fractuur is opgetreden.
De symptomen bij OSA, uitgaande van het axiale skelet, zijn afhankelijk van de locatie. Soms is er alleen sprake van een zwelling in het gebied, zoals vaak gezien wordt bij OSA uitgaande van de ribben. Bij betrokkenheid van de kaak kunnen eetproblemen een rol spelen of pijnlijkheid bij het openen van de mond. Maar ook duidelijke misvorming van de kop met exopthalmus of neusuitvloeiing kunnen afhankelijk van de precieze locatie optreden.
Theoretisch zouden er respiratoire problemen kunnen opvallen door de aanwezigheid van longmetastasen. Dit treedt echter zelden op en zelfs honden met radiologisch zichtbare longmetastasen blijven vaak maanden lang asymptomatisch. Veel vaker zien we non-specifieke verschijnselen zoals malaise en/of een slechte eetlust.


Figuur: Röntgenfoto’s van uitgebreide longmetastasen bij een hond met een osteosarcoom van de ileumvleugel
Diagnose en behandeling van Osteosarcomen
De verdenking op OSA ontstaat door een suggestieve anamnese en een goed uitgevoerd lichamelijk onderzoek. Een eerste stap in het stellen van de diagnose is het nemen van röntgenfoto’s, uiteraard in twee richtingen. De op de foto aanwezige afwijkingen kunnen variëren van vooral osteolyse tot bijna alleen osteoblastische of osteogenetische veranderingen. Corticale lysis, hetgeen uiteindelijk tot een pathologische fractuur kan leiden, wordt regelmatig gezien. Vaak is er een weke delen zwelling aanwezig en kan botnieuwvorming plaatsvinden in een ‘pallissade’ patroon of uitstralend als een ‘sunburst’ patroon. Als de tumor zich in de cortex uitbreidt, wordt het periost opgelicht en wordt er nieuw bot afgezet onder het periost. Dit leidt tot de vorming van een driehoek-vormige depositie van nieuwgevormd bot aan de randen van de laesie. Deze periostale botnieuwvorming wordt wel de ‘Codman driehoek’ genoemd. Ondanks dat dit vaak gerelateerd is aan een OSA, is het GEEN pathognomonisch teken voor OSA.
Voor het bevestigen van de diagnose is het nemen van een botbiopt noodzakelijk. Cytologie is vaak niet voldoende om een definitieve diagnose te krijgen, echter het nemen van een cytologisch biopt is snel en goedkoop en in combinatie met anamnese, lichamelijk onderzoek en röntgenfoto’s kan het wel een waarschijnlijkheidsdiagnose geven, die voldoende sterk is om met de eigenaar in overleg te kunnen over eventuele verdere diagnostiek, behandelingsmogelijkheden en prognose. In de meeste gevallen wordt de definitieve diagnose gesteld aan de hand van een histologisch biopt. Voor het nemen van een histologisch biopt zijn de Jamshidi biopsienaalden bij uitstek geschikt (zie figuur 64). Daarnaast zijn er tegenwoordig ook alternatieve biopsienaalden met bijvoorbeeld een zagend uiteinde. Het is van belang de bioptieplaats goed te plannen, zodat bij een volgende (eventueel pootsparende) operatie de bioptieplaats en het biopsiekanaal volledig verwijderd worden, zonder dat het operatieplan aangepast behoeft te worden.


Figuur: De Jamshidi botbiopsie naald en een alternatieve biopsienaald met een zagend uiteinde.
Gezien het agressieve gedrag van OSA met zeer snelle en frequente metastasering is het van groot belang de hond goed te stageren. Regionale lymfeklieren moeten worden gepalpeerd en bij vergroting worden aangeprikt. Bij het lichamelijk onderzoek moet speciaal gelet worden op pijnlijkheden bij orthopedisch onderzoek, welke kunnen wijzen op botmetastasen. Maar thoraxauscultatie en vooral thoraxfoto’s (drie opnamen; ventro-dorsaal en laterale foto’s van zowel links als rechts genomen) zijn belangrijk, ook al worden slechts in minder dan 10 procent van de gevallen op het moment van eerste aanbieding al longmetastasen aangetoond. Mogelijk zal dit percentage in de toekomst stijgen door het meer beschikbaar komen van CT-scans. De rol van scintigrafie voor het aantonen van botmetastasen is nog enigszins onduidelijk. Verschillende onderzoeken tonen aan dat er weliswaar vaak ‘hot-spots’ gevonden worden, maar dat dit niet specifiek is voor de aanwezigheid van botmetastasen. Vaak biopteren van deze ‘hot-spots’ is noodzakelijk om uit te maken of het metastasen betreft.

Tabel: Graderingsysteem voor canine osteosarcomen
Osteosarcomen worden volgens een zogenaamd chirurgisch stageringsysteem gestageerd. Dit systeem is gebaseerd op de histologische graad (G) van het OSA, de anatomie van de primaire tumor (T) en de aanwezigheid van regionale metastasen of metastasen op afstand (M). Er worden 3 stages onderscheiden:
- Stage I : low-grade (G1) tumoren zonder aanwijzingen voor metastasen
- Stage II : high-grade (G2) tumoren zonder aanwijzingen voor metastasen
- Stage III : tumoren met aantoonbare metastasen (onafhankelijk van graad)
Deze stages worden verder onderverdeeld aan de hand van de anatomie van de primaire tumor:
A : intra-compartimentaal
B : extra-compartimentaal

Figuur: Ook grote honden kunnen uitstekend op drie poten uit de voeten. Deze hond slaagde er zelfs in om na de chemotherapie op een onbewaakt moment gedekt te worden en kreeg twee prachtige gezonde pups.
Amputatie van de poot waarin de tumor zich bevindt is de standaard lokale therapie voor appendiculair OSA. Er wordt nog wel eens beweerd dat deze ingreep alleen bij kleine honden kan worden uitgevoerd, maar zelfs grote honden of reuzenrassen kunnen zich na pootamputatie uitstekend redden. De aanwezigheid van enige artrose in andere poten hoeft niet altijd een contra-indicatie voor pootamputatie te zijn. Meestal zijn deze dieren ten tijde van de diagnose dermate pijnlijk dat ze de betreffende poot al niet meer belasten en als het ware al op drie poten lopen. Dit is ook de reden dat het post-operatieve herstel en de aanpassing aan het lopen op drie benen in het algemeen zeer snel gaat (enkele dagen). Als de voorpoot aangedaan is, verdient het bij operatie aanbeveling de gehele poot inclusief schouderblad te verwijderen. Ten eerste creëren we op deze manier een ruime marge en ten tweede zien we anders dat, ten gevolge van spieratrofie van de voorpoot, de spina scapula uit zal gaan steken en dit kan bij het liggen pijnlijkheid veroorzaken. Bij een aangetaste achterpoot wordt ook een hoge amputatie aanbevolen.
Zit het OSA distaal in de poot, dan kan overwogen worden om de operatie op een dusdanig niveau uit te voeren dat later een prothese aangemeten kan worden. Wel is van belang er altijd zorg voor te dragen dat de marge voldoende blijft.


Figuur: Als de hond geen kandidaat is voor pootamputatie, of als de eigenaar niet bereid is om een pootamputatie uit te voeren en de locatie van de tumor staat het toe, kan een operatie worden uitgevoerd waarbij niet de hele poot wordt geamputeerd. Er wordt een stomp gecreëerd waarop dan een prothese geplaatst kan worden.
Als de hond geen kandidaat voor pootamputatie is door andere orthopedische problemen of omdat de eigenaar niet bereid is om een pootamputatie uit te laten voeren, kan in geschikte gevallen een pootsparende operatie uitgevoerd worden. Hiervoor zijn verschillende technieken beschikbaar, waarbij gebruik gemaakt wordt van allograft bot, een gepasteuriseerde tumorale autograft of een metalen endoprothese. Het gaat te ver om deze methoden hier te bespreken, maar men moet zich realiseren dat deze methoden in het algemeen veel kostbaarder zijn en meer kans op complicaties met zich meebrengen dan een pootamputatie.
Naast chirurgie kan ook radiotherapie een rol spelen bij pootsparende behandelingen. Bij de eerste methode, de intra-operatieve (extracorporale) radiotherapie, wordt het aangetaste bot vrijgeprepareerd en boven of onder de tumor doorgezaagd zodat het opzij bewogen kan worden. Nu kan het aangetaste bot met een zeer hoge dosis (70Gy) bestraald worden, terwijl de rest van het gezonde weefsel buiten de stralingsbundel gehouden wordt. Daarna wordt het bot weer gereponeerd en met een plaat gefixeerd. Bij een tweede methode wordt het bot na vrij prepareren boven en onder de tumor doorgezaagd en wordt het botstuk met tumor uit het lichaam genomen en dan bestraald. Vervolgens wordt het botstuk teruggeplaatst en met een plaat gefixeerd.
Bij stereotactische radiochirurgie wordt door een lineaire versneller, gekoppeld aan een CT, een driedimensionaal door een computer berekend bestralingsplan uitgevoerd, waarmee een zeer hoge dosis straling in de tumor verkregen kan worden, terwijl de omliggende weefsels gespaard worden. Grote voordeel van deze methode is dat er niet geopereerd behoeft te worden.
Bovenstaande chirurgische ingrepen gaan over appendiculair OSA, maar ook bij andere vormen van OSA is chirurgie de behandelwijze van voorkeur. Bij OSA van de mandibula of maxilla geeft het uitvoeren van een (partiële) mandibulectomie of maxillectomie goede resultaten. Bij rib OSA wordt een resectie van een deel van de thoraxwand goed verdragen en bij een OSA aan de proximale zijde van het scapula kan een partiële scapulectomie worden uitgevoerd en hoewel honden in het algemeen wat langer nodig hebben om volledig te herstellen, kunnen zij na verloop van tijd de betreffende poot weer volledig gebruiken.
Gezien de zeer hoge kans op metastasering (ondanks het feit dat slechts in 10 procent van de gevallen al metastasen gezien worden bij de diagnose) is een multimodale therapie nodig bij het behandelen van honden met OSA. De operatieve verwijdering van de tumor zal daarom altijd opgevolgd moeten worden door een adjuvant chemotherapeutische behandeling. Er bestaan vele verschillende chemotherapie protocollen maar de meest gebruikte zijn zes keer doxorubine/epirubicine (elke drie weken) of afwisselend drie keer doxorubicine/epirubicine en carboplatin (elke drie weken, in totaal zes behandelingen).
Vrijwel alle honden met OSA ontwikkelen op een gegeven moment longmetastasen; humaan wordt de chirurgische verwijdering van dergelijke metastasen beschreven. Veterinair moeten we zeer terughoudend zijn met dergelijke ingrepen, omdat de zwaarte van de ingreep en het post-operatieve herstel moeten opwegen tegen de tijdwinst die voor het dier behaald wordt. Er zijn criteria opgesteld om te bepalen of het verwijderen van longmetastasen van OSA (ethisch gezien) te verantwoorden is:
- De primaire tumor moet compleet in remissie zijn en het liefst moet er sprake zijn van een lang relapse-free interval (langer dan driehonderd dagen)
- Slechts één of twee noduli zichtbaar op de thoraxfoto
- Alleen metastasen in de longen (negatieve botscan)
- Lange tumor doubling time (tijd waarin de tumor in omvang verdubbelt) van minimaal dertig dagen, waarin ook geen nieuwe noduli mogen ontstaan.
Naast chirurgie lopen er op dit moment ook onderzoeken naar het gebruik van de tyrosine kinase inhibitor Palladia ter behandeling van macroscopisch zichtbare metastasen.
Als de eigenaar na het stellen van de diagnose aangeeft dat hij operatie geen optie vindt, er andere (orthopedische) problemen aanwezig zijn waardoor de hond geen operatiekandidaat is of er al uitgebreide metastasering is opgetreden, zal gekozen moeten worden voor een palliatieve behandeling. Het belangrijkste doel van deze behandeling is het verminderen van de pijn die door de hond ervaren wordt.
Hiervoor bestaan, naast de medicamenteuze behandeling met NSAIDs en opiaten, nog twee andere mogelijkheden:
- Aminobifosfanaten (paminodraat, fosamax). Deze middelen zijn vooral bekend van het humane gebruik bij non-neoplatische resorptieve botaandoeningen zoals osteoporose. Daarnaast zijn de middelen humaan ook een deel van de eerstelijns behandeling van maligne osteolytische processen zoals multiple myeloma of botmetastasen. Veterinair wordt Paminodraat het meest gebruikt. Paminodraat wordt gegeven in een dosering van 1 mg/kg opgelost in een fysiologisch zoutoplossing en toegediend via een intraveneus infuus over een tijdsperiode van minimaal 30 minuten één keer per vier weken. Hoewel studies ontbreken lijkt ook het geven van orale aminofosfanaten (Fosamax) een effectieve pijnverlichting te geven.
- Radiotherapie. Radiotherapie wordt beschouwd als de meest effectieve behandeling van osteolytische botpijnen bij de mens. Het pijnstillende effect wordt veroorzaakt door de veroorzaakte apoptose van maligne osteoblasten en osteoclasten. Er bestaan verschillende bestralingsschema’s voor de palliatieve pijnbestrijding bij OSA, maar wij gebruiken het schema met drie bestralingen op dag 0,7 en 21. Bij verreweg het grootste deel van de patiënten (80 procent) wordt een duidelijke afname van de pijnklachten gezien.
- Chemotherapie. Er zijn aanwijzingen dat het gelijktijdig toedienen van chemotherapie de mate en duur van het pijnstillende effect van radiotherapie kunnen versterken. Daarnaast zou de overlevingstijd verlengd kunnen worden, doordat ook het optreden van metastasen vertraagd wordt door het geven van chemotherapie.
Prognose
De prognose voor honden met appendiculair OSA na pootamputatie zonder adjuvante behandeling is slecht, met een mediane overlevingstijd van minder dan drie maanden. Als pootamputatie gecombineerd wordt met adjuvant chemotherapie wordt de overlevingstijd significant verlengd tot 40 tot 50 procent van de honden een jaar na operatie nog in leven en 10 tot 20 procent van de honden die langer dan twee jaar overleven. Uiteindelijk zal 90 procent van de honden uiteindelijk aan de gevolgen van metastasering overlijden. Voor non-appendiculaire OSA zijn de overlevingstijden vergelijkbaar. Uitzondering vormt het mandibulaire OSA waarvoor een 70 procent overlevingspercentage op een jaar post-operatief (zonder adjuvant chemotherapie) wordt aangegeven.
Er zijn inmiddels een groot aantal prognostische factoren bekend, die helpen de prognose van de individuele patiënt beter in te schatten.
Dieren jonger dan vijf jaar blijken na pootamputatie bij appendiculair OSA een kortere overleving te hebben dan honden ouder dan vijf jaar. Daarnaast zijn ook de grootte van de tumor en de locatie (humerus = ongunstig) prognostische factoren. Bij OSA, uitgaande van platte beenderen, zijn kleine rassen en volledige verwijdering positieve prognostische factoren. Maar ook hier speelt locatie een rol: voor OSA aan de kop (mandibula, maxilla en schedel) geldt dat deze lokaal agressief zijn, maar minder vaak uitzaaien dan appendiculaire OSA. Het gedrag van de overige non-appendiculaire osteosarcomen is vergelijkbaar met appendiculaire OSA.
Voor appendiculaire OSA is de graad van het OSA prognostisch van belang waarbij graad III tumoren een significant slechtere prognose hebben dan graad I en II tumoren. Voor niet-appendiculaire tumoren blijkt de tumorgraad echter geen prognostische waarde te hebben.
Naast graad van het OSA en locatie worden ook een verhoogde serum alkalisch fosfatase spiegel en vasculaire ingroei van de tumor als negatieve prognostische factoren genoemd.

Beslisboom voor honden met osteosarcomen
Casus Jack
Patiënt: Jack, een Amerikaanse Bulldog reu van 8 jaar
Klacht
Jack heeft sinds een week last van kreupelheid linksvoor en is door de eigen dierenarts voor nader onderzoek en behandeling doorgestuurd. De eigen dierenarts heeft röntgenfoto’s gemaakt van het linker ellebooggewricht. Een uitgebreid bloedonderzoek laat geen afwijkingen zien. De differentiële diagnose luidt arthrose of een bottumor. Er is geen voorafgaand trauma aan dit gewricht bekend. Wel is Jack aan twee kanten geopereerd aan een ruptuur van de voorste kruisband. Hij krijgt nu firocoxib (Previcox®) en loopt redelijk. Jack is niet in het buitenland geweest en heeft geen ontstekingsprocessen gehad. De meegebrachte röntgenfoto’s vertonen osteolyse van de mediale humeruscondyl links, met iets periostale proliferatie.
Klinische bevindingen
Bij een algemeen onderzoek worden geen bijzonderheden gevonden, behalve dan aan het linker ellebooggewricht. Het buigen en strekken is pijnlijk, waarbij sprake is van crepitaties. De linker mediale humeruscondyl is dubieus en iets grover dan rechts.
Aanvullend onderzoek
Er worden een thoraxfoto en een thorax CT-scan gemaakt. Hierop zijn geen aanwijzingen zichtbaar voor metastasen. De CT-scan van de linker elleboog toont verlies van botstructuur en cortexverval van de mediale humerus condyl, met aan de distale zijde volledige lysis van de cortex grenzend aan het ellebooggewricht en infiltratie van het proces in het gewricht (zie CT-scan). Differentieel diagnostisch wordt gedacht aan een bottumor of osteomyelitis.


De CT-scan van de linker elleboog.
Besloten wordt om via een ‘bone-window’ een DN(A)B te nemen van het proces. Het punctaat is sterk hemorrhagisch en 20 uitstrijkjes worden opgestuurd voor cytologisch onderzoek.
Uitslag cytologie: cellulair aspect maligne mesenchymale tumor, passend bij osteosarcoom.
Behandeling
De beste behandeling lijkt amputatie en de kans dat Jack hier goed mee omgaat (ondanks beiderzijdse kruisbandoperatie) is reëel. Alternatief is een palliatieve behandeling die kan bestaan uit analgetica, ontstekingsremmers, locale radiotherapie met een lineaire versneller of systemische radiotherapie met Samarium-153. In overleg met de eigenaar wordt besloten de linker voorpoot te amputeren, inclusief de scapula. De rechtvaardiging voor deze beslissing is gebaseerd op de differentiële diagnose van het letsel, maar ook op het feit dat gezien de destructie van het gewricht de kans op een functioneel ellebooggewricht bij een pootsparende behandeling niet reëel lijkt. Na de pootamputatie worden radius/ulna, ellebooggewricht en humerus voor histopathologisch onderzoek opgestuurd.
Nabehandeling
De genezing verloopt ongecompliceerd. Tien dagen na de operatie volgt een behandeling met een intramusculaire Slow Release Carboplatin-injectie, uitgaande van het feit dat osteosarcoom nog steeds de belangrijkste differentiële diagnose is. Bloedonderzoek toont een Ht van 0,39 en een leucocytose door granulocytose. Hiervoor krijgt Jack nog 14 dagen amoxycilline/clavulaanzuur (Synulox®) per os.
Eén maand na amputatie volgt de definitieve uitslag van het histopathologisch en immunohistochemisch onderzoek: Plasmacytoïde tumor, Kappa lichte keten positief, en negatief voor CD3- en CD79a-antigenen. Op basis van de gecombineerde microscopische bevindingen dient er rekening te worden gehouden met een multipel myeloom.
De eigenaar krijgt uitgebreid advies over de controle op het ontstaan van multipel myeloom, waarvan op dat moment nog geen tekenen aanwezig zijn. Bij de eigen dierenarts zal regelmatig naast een algemeen klinisch onderzoek, een bloedonderzoek worden verricht: hematologie, calcium en totaal eiwit met eiwitspectrum om te kijken of er geen monoclonale piek in de gammaglobuline-fractie ontstaat.
De daaropvolgende bloedonderzoeken vertonen, behalve een langzame stijging van de beta-globulines met een hoog-normaal totaal eiwitgehalte, geen afwijkingen. Deze stijging zou veroorzaakt kunnen zijn door een migratie van een monoclonaal gamma-globuline in de Beta-fractie, door een verandering in electrische lading van dit eiwit (zie elektroforese). Een immuunelectrophorese is niet uitgevoerd evenals urineonderzoek op Bence-Jones eiwitten, gezien de slechte beschikbaarheid van deze testen.

Vervolg
Bijna 9 maanden na de operatie wordt Jack opnieuw doorverwezen. Sinds 1 maand zijn er diverse diktes ontstaan in huid en subcutis. De laatste 2 weken zijn deze duidelijk in omvang toegenomen. Ook krijgt de hond meer last van de rechter achterpoot. Door de eigen dierenarts zijn DNAB’s van de diktes genomen. Uitslag pathologielaboratorium(niet-GD): sarcoom.
Bij klinisch onderzoek worden inderdaad diverse intradermale en subcutane diktes gevonden, die in diameter variëren van een paar mm tot 4 cm. Röntgenfoto’s van het skelet laten geen focale osteolytische letsels zien, veroorzaakt door multipel myeloom. Aanvullend bloedonderzoek laat geen afwijkingen zien, maar een serumeiwitelectrophorese werd niet meer uitgevoerd.
Met een 14G Vet-Core biopsienaald worden uit verschillende diktes 5 biopten genomen voor histopathologisch onderzoek.
Uitslag histopathologie inclusief immuunhistochemie: de cel- en kernmorfologie van de biopten, afkomstig van diverse plaatsen in huid/subcutis, komen overeen met de eerder gediagnosticeerde plasmacytoïde tumor in de linker humerus condyl, c.q. er is sprake van een multipel myeloom.
Behandeling
Jack wordt behandeld met prednisolon (Prednoral®) en melphalan (Alkeran®) per os en krijgt tramadol bij erge pijnlijkheid.
Bij de controle na één maand blijkt dat de meeste diktes of volledig verdwenen of nog heel gering voelbaar zijn. Er is alleen nog één dikte van 2 cm doorsnee in huid aan de rechter zijde van de hals voelbaar. Rechts achter is er sprake van spieratrofie en Jack lijkt deze poot ook wat te ontzien. Verder worden geen bijzonderheden gevonden. Bloedonderzoek laat ook geen afwijkingen zien.
Uiteindelijk verdwijnen alle diktes en wordt de behandeling veranderd in melphalan en firocoxib, mede in verband met progressieve spieratrofie door het chronische prednisolongebruik en de toename van de locomotieproblemen.
Na een half jaar ontstaan er weer wat meer diktes in/onder de huid, ontziet Jack de rechter voorpoot en krijgt hij ook steeds meer problemen met de achterhand. Orthopedisch onderzoek wijst uit dat hierbij sprake is van een neurologisch probleem met uitval rechtsachter en staartparalyse. De eigenaar wil hiervan geen uitgebreid aanvullend onderzoek meer. De behandeling met firocoxib wordt gestopt en opnieuw wordt gestart met de toediening van corticosteroïd, maar nu met methylprednisolon (Moderin®) per os. Op de rechter voorpoot zit een dikte rond het MC-Ph gewricht van digit 4, waarvan een DNAB wordt genomen. Uitslag cytologie: cellulair aspect rondceltumor.Op basis van deze uitslag wordt besloten de dosering melphalan weer iets te verhogen.
Uiteindelijk nemen de locomotieproblemen in de achterhand toe en wordt besloten om Jack op 10-jaar oude leeftijd te euthanaseren. De totale overlevingsduur bedraagt 1,5 jaar.
Toelichting pathologie
Deze gedetailleerd beschreven casus toont een realistisch samenspel tussen de behandelend dierenarts en de patholoog. De behandelend dierenarts heeft op basis van het klinische en beeldvormende onderzoek een differentiële diagnose gesteld, waarbij het osteosarcoom op de eerste plaats staat. Aanvullend pathologisch onderzoek heeft als doel om zoveel mogelijkheid zekerheid te bieden bij de ontrafeling van deze differentiële diagnose. In dit geval is in eerste instantie gekozen voor aanvullend cytologisch onderzoek. De resultaten hiervan dragen gezien het verdere verloop van deze casus helaas niet bij aan de juiste diagnose. Immers, de uitslag van het cytologische onderzoek luidt dat er sprake is van een sarcoom, mogelijk een osteosarcoom overeenkomstig de klinische waarschijnlijkheidsdiagnose. Na pootamputatie wordt aanvullend histopathologisch onderzoek verricht; dit type onderzoek vertegenwoordigt nog steeds de gouden standaard binnen de pathologische diagnostiek. De histopathologische diagnose werpt een totaal ander licht op de aard van de aandoening. Nu blijkt er sprake te zijn van een maligne rondceltumor, die plasmacytoide differentiatie vertoont, gezien de expressie van Kappa lichte ketens. De wezenlijke betekenis van deze histopathologische en immuunhistochemische diagnose is dat de plasmacytoide differentiatie van de tumor duidt op een hematopoetische oorsprong en dat er dus in principe sprake is van een primair multipele maligne tumor. Hierdoor moet er rekening mee worden gehouden dat deze tumor ook al elders in het lichaam aanwezig is of zich op termijn op andere plekken in het lichaam zal manifesteren.

De linker foto toont de tumor na ontkalking in Osteosoft (HE kleuring). De celkenmerken kunnen goed beoordeeld worden na deze relatief milde ontkalkingsvorm. Op deze foto is te zien dat de tumorcellen niet ingebed liggen in een stromale component en dat er dus geen sprake is van een sarcoom, maar van een maligne rondceltumor met een waarschijnlijke hematopoeitische oorsprong. De rechter foto toont de resultaten van immuunhistochemisch onderzoek naar de expressie van Kappa lichte ketens. De tumorcellen tonen cytoplasmatische expressie hiervan, duidend op een plasmacytoide differentiatie. Door de localisatie van het proces en deze microscopische kenmerken dient rekening te worden gehouden met een multipele myeloom.
Drs. Johan de Vos, DierenZiekenhuis Zeeuws-Vlaanderen
Het nemen en versturen van een botbiopt
Wanneer er sprake is van botafwijkingen is het in veel gevallen mogelijk om op basis van signalement, anamnese, klinische verschijnselen, röntgenfoto’s en eventueel CT-scan een waarschijnlijkheidsdiagnose te stellen. Deze diagnose kan met behulp van histopathologie worden onderbouwd of aangepast. Bij verdenking op een tumor of een ander proces in het bot, waarbij een medicamenteuze behandeling zonder amputatie tot de opties behoort, is een botbiopt de aangewezen methode om tot de juiste diagnose en behandeling te komen. Botbiopten kunnen op verschillende manieren worden genomen, waarbij de verschillende methoden specifieke vóór- en nadelen hebben.
Open incisie biopt
Met behulp van een open incisie biopt (niet te oppervlakkig genomen) is het mogelijk om een groot biopt te verkrijgen, waardoor een accurate diagnose kan worden gesteld. De ingreep is echter vrij invasief en het risico op post-operatieve complicaties zoals hematoomvorming, infecties, tumor seeding en pathologische fracturen is groot.
Jamshidi beenmerg bioptnaald
Het nemen van een biopt met een Jamshidi beenmerg bioptnaald (zie foto) verdient verreweg de voorkeur. Onderzoek heeft aangetoond dat met een Jamshidi naaldbiopt met 92% zekerheid onderscheid kan worden gemaakt tussen een tumor en andere aandoeningen en dat met 82% zekerheid het specifieke tumor subtype kan worden bepaald. Het biopsiekanaal dient zo te worden gelokaliseerd dat dit (in verband met de kans op “tumor seeding”) ten tijde van de chirurgische ingreep compleet kan worden verwijderd. De periferie van een bottumor kan uit reactief weefsel bestaan, hetgeen tot een foutieve diagnose kan leiden. Een “lege artis” uitgevoerd biopt wordt dus cortex-to-cortex uitgevoerd om representatief materiaal te verkrijgen. Het is belangrijk dat deze, met veel zorg verkregen, botbiopten ongefragmenteerd en in een volledig afgevuld potje formaline naar het pathologielaboratorium worden gestuurd. Er mag zich geen luchtkamer of zelfs luchtbel boven de formaline in het potje bevinden, omdat anders de vloeistof tijdens het transport gaat klotsen, waardoor de biopten vrijwel zeker tijdens het transport alsnog zullen fragmenteren.
Bij pootsparende operaties zal deze bioptname vanwege tumorverspreiding en het niet kunnen verwijderen van het biopsiekanaal geen optie zijn.
Trephine biopten
Het nemen van trephine biopten wordt sterk afgeraden, vanwege de veelal ernstige (warmte)artefacten die in het biopt ontstaan tijdens het nemen van het biopt, waardoor vaak geen goed histopathologisch onderzoek kan volgen.
DN(A)B
Een DN(A)B behoort ook tot de opties. Hierbij dient een ‘bonewindow’ te worden opgezocht middels röntgenfoto’s, een echo, of een CT-scan. De uitslagen van de cytologie leiden niet altijd tot een diagnose. Necrosehaarden die veelvuldig in primaire bottumoren voorkomen kunnen de oorzaak zijn voor het verkrijgen van een niet-representatief aspiraat op basis waarvan geen cytologische diagnose gesteld kan worden.
Het nemen van meerdere biopten vergroot de diagnostische zekerheid. Osteosarcomen zijn heterogeen samengestelde tumoren en bij te kleine en te oppervlakkige biopten, bestaat een reële kans op een verkeerde diagnose zoals hemangiosarcoom, fibrosarcoom of chondrosarcoom. Voordat het botbiopt in de formaline wordt geplaatst, kunnen er eventueel nog monsters voor bacteriologisch of cytologisch onderzoek worden genomen.
Indien wordt besloten tot een pre-operatief botbiopt, is post-operatief histo-pathologisch onderzoek van de complete tumor raadzaam om de diagnose te kunnen bevestigen.
De snelheid van de uitslag van botbiopten is cruciaal. De biopten moeten worden ontkalkt en dit proces vergt tijd. Dit laatste staat op gespannen voet met het belang van een snelle diagnose. Meer over de verschillende ontkalkingsprocedures met hun specifieke voor- en nadelen, ook met betrekking tot de tijdsduur van de ontkalking bij de GD lees je hier.
Wanneer ligt een botbiopt niet voor de hand?
Als het letsel op basis van de klinische verschijnselen en beeldvorming suggestief is voor een primaire bottumor en verwijdering van de volledige tumor door middel van pootamputatie of een pootsparende operatie de enig overblijvende behandeling is, zal een botbiopt geen toegevoegde waarde hebben. Bovendien zal het tot onnodig tijdverlies en onnodige kosten leiden. Als wordt gekozen voor een palliatieve behandeling, is het ook de vraag of een botbiopt een toegevoegde waarde heeft
Na pootamputatie of locale verwijdering van het proces kan vervolgens door middel van histopathologisch onderzoek de diagnose worden gesteld, waarbij ook op basis van microscopische parameters een prognostische inschatting kan volgen (osteosarcoom graderingsschema door Kirpensteijn et al.).
Dit artikel behandelt de botbiopten van de lange beenderen. Biopten van de overige botten vereisen een andere aanpak, omdat daarbij ook sprake kan zijn van invasieve weke delen tumoren.
Met dank aan: Drs. Johan de Vos, DierenZiekenhuis Zeeuws-Vlaanderen
Literatuur:
Kirpensteijn J, Kik M, Rutteman GR, Teske E. Prognostic significance of a new histologic grading system for canine osteosarcoma. Veterinary pathology. 2002; 39: 240-246
Powers BE, LaRue SM, Withrow SJ, Straw RC, Richter SL. Jamshidi needle biopsy for diagnosis of bone lesions in small animals. Journal of the American Veterinary Medical Association. 1988 Jul; 193(2): 205-210
Tangner S. Bone Biopsy. Seminars in veterinary medicine and surgery (small animal). 1993 Nov; 8(4): 245-249
Withrow S, Vail D. (2007). Withrow and MacEwen’s Small animal clinical oncology (4th edition). Missouri: Saunders Elsevier.
Withrow S, Liptak J, Ehrhart N, Dernell W. Canine Appendicular Osteosarcoma: Diagnosis and Palliative Treatment. Compendium of Continuing Education for the Practicing Veterinarian. 2004 (March): 172-182.
Ontkalkingsprocedures voor bothoudend weefsel
Voordat microscopisch onderzoek van botweefsel mogelijk is, zijn een aantal bewerkingen in het laboratorium nodig. Om het weefsel te kunnen snijden met een microtoom tot microscopische coupes, dient het botweefsel eerst ontkalkt te worden. Dit proces neemt enige tijd in beslag. Hieronder wordt ingegaan op de ontkalkingsprocedures voor bothoudend weefsel ten behoeve van microscopisch onderzoek.
Door de ontkalking worden de verschillende bothoudende compartimenten, zoals het compacte been in de cortex en het trabeculaire, spongieuze been in het merg, gedemineraliseerd. Daarna kan het weefsel tot coupes worden gesneden, geschikt voor microscopisch onderzoek.
Pijpbeenderen, of delen hiervan, worden eerst door middel van een speciale diamantzaag tot dunne plakjes gezaagd, waarbij de keuze van de zaagsnedes in belangrijke mate wordt bepaald door informatie op het inzendformulier over de lokalisatie van het proces. Kleine Jamshidi naaldbiopten worden in de regel direct na het ontkalkingsproces verwerkt tot coupes ten behoeve van het microscopische onderzoek.
Eisen aan het ontkalkingsproces
De ontkalking is een kritische stap in het verwerkingsproces van botweefsel. De volgende eisen worden aan de ontkalkingsprocedure gesteld:
- Het ontkalkingsproces dient zo weinig mogelijk tijd in beslag te nemen, zodat zo snel mogelijk na ontvangst van het weefsel een histopathologische diagnose mogelijk is.
- Het ontkalkingsproces dient zo weinig mogelijk negatieve effecten te hebben op de morfologische kwaliteit van het weefsel, zodat het weefsel microscopisch goed te beoordelen is.
Om doel 1 te kunnen bereiken is het in de eerste plaats van belang dat de gezaagde weefselplakjes, die ontkalkt moeten worden, zo dun mogelijk zijn. Voor de chemische ontkalking van het bot bestaan verschillende mogelijkheden, elk met hun specifieke voor- en nadelen met betrekking tot doel 1 en doel 2.
Ontkalking door middel van minerale of organische zuren
Van oudsher wordt botweefsel ontkalkt door middel van minerale of organische zuren. Voorbeelden van minerale zuren zijn oplossingen van salpeterzuur of zoutzuur. Ontkalkingsprocedures gebaseerd op deze minerale zuren verlopen snel, waardoor doel 1 in de regel binnen een week bereikt wordt. Echter, minerale zuren zijn niet goed verenigbaar met doel 2 en kunnen, zeker wanneer het eindpunt van de ontkalking niet goed wordt vastgesteld en weefsel te lang in deze zuren geïncubeerd wordt, leiden tot desastreuze effecten op de morfologische kwaliteit van het weefsel, waardoor de microscopische beoordeling sterk bemoeilijkt wordt of soms zelfs niet meer mogelijk is. In plaats hiervan kunnen ook organische zuren worden gebruikt voor de ontkalking. Een bekend organisch zuur is mierenzuur, dat in een bepaalde concentratie een redelijk compromis vormt bij het bereiken van het doel 1 en doel 2. Echter, ook bij gebruik van organische zuren dient te allen tijde worden voorkomen dat weefsel onnodig lang wordt geïncubeerd in de ontkalkingvloeistof.
Chelatie ontkalkingsprocedure
Vanwege de mogelijke negatieve effecten van minerale zuren, en in mindere mate organische zuren, op de morfologische kwaliteit van het weefsel wordt in de diagnostiek vaak ook gekozen voor een type ontkalking die gebaseerd is op het onttrekken van calciumzouten aan het bot door middel van chelatie. EDTA is zo'n chelatie middel. Een 10-14% oplossing van di-natrium-EDTA, commercieel verkrijgbaar als Osteosoft®, ontkalkt een botbiopt dat verkregen is door middel van een Jamshidi-naald, in de regel binnen 7-10 dagen. De tijdsduur die nodig is voor de ontkalking van dergelijke kleine botbiopten maakt duidelijk dat een chelatie ontkalkingsprocedure relatief traag verloopt en dit staat op gespannen voet met doel 1. Toch kiest de GD voor het microscopische onderzoek van kleine botbiopten vrijwel standaard voor deze ontkalkingsprocedure, omdat door middel van deze ontkalking aan de eisen die gesteld worden bij doel 2 vrijwel optimaal tegemoet wordt gekomen. Chelatie is vanwege de relatief trage ontkalking minder geschikt voor het onderzoek van grotere botfragmenten.
Eindpunt ontkalkingprocedure
Het correct vaststellen van het eindpunt van een ontkalkingsprocedure is dus van groot belang. Dit kan in de regel redelijk goed worden vastgesteld door middel van het voorzichtig buigen van het ontkalkte weefsel. Wanneer het weefsel buigbaar is en daarbij niet breekt, is de ontkalking zodanig gevorderd dat het mogelijk moet zijn om hiervan coupes te vervaardigen. Een meer objectieve methode om het eindpunt van een ontkalkingsprocedure vast te stellen maakt gebruik van de chemische eigenschappen van calcium. Calcium dat als gevolg van de ontkalkingsprocedure aan het botweefsel is onttrokken en zich in de ontkalkingvloeistof bevindt, vormt een kristallijn neerslag in de vorm van calciumoxalaat als, ter controle op de voortgang van de ontkalking, ammoniumoxalaat aan de vloeistof wordt toegevoegd. Zolang zich een dergelijk neerslag vormt is het botweefsel nog niet volledig ontkalkt. Op het moment dat zich geen neerslag meer vormt, mag geconcludeerd worden dat het botweefsel volledig ontkalkt is. Dit is dan ook het moment dat het ontkalkingsproces gestopt dient te worden, zodat overmatige incubatie van het weefsel met ontkalkingvloeistof wordt voorkomen.
Aanvullend immuunhistochemisch onderzoek
Tenslotte moet nog worden vermeld dat ontkalkingsprocedures kunnen interfereren met de mogelijkheid tot aanvullend immuunhistochemisch onderzoek op botweefsel. Zeker bij gebruik van minerale of organische zuren kunnen structuurveranderingen optreden in niet-lineaire epitopen, waardoor een antilichaam niet meer kan binden aan het bijbehorende epitoop, zodat er een vals-negatief resultaat van het immuunhistochemische onderzoek kan optreden.
Ontkalkingsprocedures die gebaseerd zijn op chelatie hebben veel minder negatieve gevolgen voor aanvullend immuunhistochemisch onderzoek. Tot op dit moment is niet in kaart gebracht op welke immuunhistochemische kleuringen de verschillende ontkalkingsprocedures een negatief effect hebben.
NB: bovenstaand heeft geen betrekking op de verwerking van botweefsel wanneer het pathologische onderzoek zich toespitst op de mineralisatiegraad van het bot. Voor dergelijk onderzoek wordt het botweefsel niet ontkalkt.








